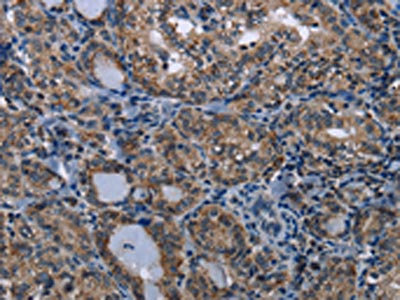

TRPV1 Antibody
-
中文名稱:TRPV1兔多克隆抗體
-
貨號:CSB-PA037727
-
規格:¥1100
-
圖片:
-
The image on the left is immunohistochemistry of paraffin-embedded Human thyroid cancer tissue using CSB-PA037727(TRPV1 Antibody) at dilution 1/20, on the right is treated with synthetic peptide. (Original magnification: ×200)
-
The image on the left is immunohistochemistry of paraffin-embedded Human brain tissue using CSB-PA037727(TRPV1 Antibody) at dilution 1/20, on the right is treated with synthetic peptide. (Original magnification: ×200)
-
-
其他:
產品詳情
-
Uniprot No.:
-
基因名:
-
別名:Capsaicin receptor antibody; DKFZp434K0220 antibody; osm 9 like TRP channel 1 antibody; Osm-9-like TRP channel 1 antibody; OTRPC1 antibody; Transient receptor potential cation channel subfamily V member 1 antibody; TRPV 1 antibody; Trpv1 antibody; TRPV1_HUMAN antibody; Vanilloid receptor 1 antibody; Vanilloid receptor subtype 1 antibody; VR 1 antibody; VR1 antibody
-
宿主:Rabbit
-
反應種屬:Human
-
免疫原:Synthetic peptide of Human TRPV1
-
免疫原種屬:Homo sapiens (Human)
-
標記方式:Non-conjugated
-
抗體亞型:IgG
-
純化方式:Antigen affinity purification
-
濃度:It differs from different batches. Please contact us to confirm it.
-
保存緩沖液:-20°C, pH7.4 PBS, 0.05% NaN3, 40% Glycerol
-
產品提供形式:Liquid
-
應用范圍:ELISA,IHC
-
推薦稀釋比:
Application Recommended Dilution ELISA 1:1000-1:2000 IHC 1:25-1:100 -
Protocols:
-
儲存條件:Upon receipt, store at -20°C or -80°C. Avoid repeated freeze.
-
貨期:Basically, we can dispatch the products out in 1-3 working days after receiving your orders. Delivery time maybe differs from different purchasing way or location, please kindly consult your local distributors for specific delivery time.
-
用途:For Research Use Only. Not for use in diagnostic or therapeutic procedures.
相關產品
靶點詳情
-
功能:Ligand-activated non-selective calcium permeant cation channel involved in detection of noxious chemical and thermal stimuli. Seems to mediate proton influx and may be involved in intracellular acidosis in nociceptive neurons. Involved in mediation of inflammatory pain and hyperalgesia. Sensitized by a phosphatidylinositol second messenger system activated by receptor tyrosine kinases, which involves PKC isozymes and PCL. Activation by vanilloids, like capsaicin, and temperatures higher than 42 degrees Celsius, exhibits a time- and Ca(2+)-dependent outward rectification, followed by a long-lasting refractory state. Mild extracellular acidic pH (6.5) potentiates channel activation by noxious heat and vanilloids, whereas acidic conditions (pH <6) directly activate the channel. Can be activated by endogenous compounds, including 12-hydroperoxytetraenoic acid and bradykinin. Acts as ionotropic endocannabinoid receptor with central neuromodulatory effects. Triggers a form of long-term depression (TRPV1-LTD) mediated by the endocannabinoid anandamine in the hippocampus and nucleus accumbens by affecting AMPA receptors endocytosis.
-
基因功能參考文獻:
- Correlation between heat pain threshold and TRPV1 receptor protein level over various phases of the ovarian-menstrual cycle has been reported. PMID: 29578437
- C-fibers and transient receptor potential cation channel, subfamily V, member 1 protein (TRPV 1)-mediated vasodilations are impaired in type 1 diabetes (T1D) patients. PMID: 28287157
- Src kinase mediates UV-induced TRPV1 trafficking into cell membrane in HaCaT keratinocytes. PMID: 29080357
- Disruption of the association of Sig-1R with TRPV1 by synthetic or natural antagonists leads to degradation of TRPV1 protein and to decreased levels of the ion channel protein as well as to a decrease in TRPV1-associated pain. PMID: 29378958
- A strong capacity to positively regulate skin sensitization mechanisms related to the TRPV1 receptors. PMID: 29562624
- Activation of TRPV1 channels attenuates ischemia-reperfusion-induced injury in a variety of organs including heart, kidney, lungs, and brain possibly via enhancing the discharge of calcitonin gene-related peptide and substance P PMID: 28466657
- cystinosis patients homozygous for the 57-kb deletion exhibit a strong reduction of TRPV1 function, leading to sensory deficiencies akin to the phenotype of TRPV1-deficient mice PMID: 27734949
- The TRPV1 mRNA were significantly upregulated in chronic Low Back Pain compared with controls. PMID: 28481838
- antitumor and apoptosis effects of 5-FU are up-regulated by activation of TRPV1 channels, but its action was down-regulated by HPer treatment. It seems that HPer cannot be used for increasing the antitumor effect of 5-FU through modulation of the TRPV1. PMID: 28795251
- TRPV1 interacts physically with MOR-1 and modulates MOR-1 activity in HEK293 cells. PMID: 29203659
- the expression of transient receptor potential vanilloid-1 (TRPV1), transient receptor potential vanilloid-2 (TRPV2) and transient receptor potential vanilloid-3 (TRPV3) channels in native human odontoblasts, was examined. PMID: 28905239
- activation of TRPV1, but not TRPA1 mediates a calcium-dependent cell death. PMID: 29129206
- Apoptosis and oxidant effects of cisplatin were increased by activation of TRPV1 channels, but its action on the values was further increased by the ALA treatment. Combination therapy of Alpha-lipoic acid and cisplatin could be used as an effective strategy in the treatment of breast cancer. PMID: 28849985
- Analysis of structural, dynamic, and hydrophobic organization of the pore domain revealed entropy growth upon TRPV1 gating, which is in line with current concepts of thermal sensitivity. PMID: 27612191
- TRPV5 and TRPV6 lack a positively charged residue in the TM4-TM5 loop that was shown to interact with PI(4,5)P2 in TRPV1, which shows high affinity for this lipid PMID: 27291418
- SMFAs ubiquitously express functional TRPV1 channels. PMID: 28681979
- Both TRPV1 and GRP are implied in midbrain physiology of importance to neurological and neuropsychiatric disorders. PMID: 27762319
- positive correlation between VR1 and PGE2 expression in leiomyoma cells and areas with pain around the tumors PMID: 28026039
- 5'UTR influences the stability and translation efficacy of TRPV1 transcripts, and that TRPV1 variant three (TRPV1v3) was the most stable and the only variant expressed in glioblastoma samples and in glioma stem-like cells. PMID: 27829230
- Upper gastrointestinal symptoms are more common in subjects with a higher consumption of spicy foods, younger age and female gender, regardless of TRPV1 genotypes and the H. pylori infection status. PMID: 27094759
- Mean TRPV-1 and TRPA-1 gene expression was higher in IPF patients compared with controls, but the difference did not reach statistical significance. Immunostaining supported these findings PMID: 29149168
- TRPV1 and TRPA1 also act as nociceptive sensors and potentiate the inflammatory process. PMID: 28364279
- studies identified TRPV4 as a channel that contributes to both histamine- and chloroquine-induced itch and indicated that the function of TRPV4 in itch signaling involves TRPV1-mediated facilitation. PMID: 27436359
- People with the minor alleles of the TRPV1 single nucleotide polymorphisms rs161364 and rs8065080 have a lower risk of diabetes with a high-fat diet, but people with the major alleles are at a higher risk of type 2 diabetes when consuming high-fat diets. PMID: 27287034
- The TRPV1 transcript was present in prostate cancer-affected foci, both in the tumor tissue as well as in the adjacent untransformed part of the gland. All breast carcinoma cell lines showed robust expression of TRPV1. Trigeminal ganglion expressed significantly higher levels of TRPV1 protein than either breast or prostate cancer cells. Ectopic expression of TRPV1 decreases cancer cell survival by induction of apoptosis. PMID: 27180305
- This activity is independent of the NGF pathway and is not mediated by known TRPV1 toxins' binding sites. PMID: 28063984
- It has been shown that the propagation of the TRPV1-induced cytosolic calcium and sodium fluxes into mitochondria is dependent on coordinated activity of NCLX and MCU. PMID: 27627464
- Endogenous TRPV1 stimulation leads to the activation of the inositol phospholipid pathway necessary for sustained Ca(2+) oscillations. PMID: 27663071
- The distinct localization of TRPV1 receptor, supports the concept of a role in the functional activity of the trigeminal sensory system. PMID: 27456865
- This study showed that oleoylethanolamine and palmitoylethanolamine have endogenous roles and potential therapeutic applications in conditions of intestinal hyperpermeability and inflammation. PMID: 27623929
- The slow sustained current mediated by TRPV1. PMID: 28522561
- This study suggests that the TRPV1 channel is involved in interferon beta-induced flu-like syndrome in patients with relapsing-remitting multiple sclerosis. PMID: 28284340
- Respiratory syncytial virus and measles virus infection upregulates TRPV1 expression in bronchial epithelial cells. PMID: 28187208
- These studies suggest that TRPV1 is expressed on airway smooth muscle. PMID: 28336810
- mutational analysis of human TRPV1 was performed, and four agonists (capsaicin, RTX, [6]-shogaol and [6]-gingerol) were used to identify amino acid residues involved in ligand binding and/or modulation of proton sensitivity. PMID: 27606946
- Therefore, and considering the desensitization of TRPV1s in diabetic pancreata, a TRPV1-to-secretagogin regulatory axis seems critical to maintain the structural integrity and signal competence of beta-cells. PMID: 28637794
- Acute administration of 5-hydroxytryptamine4 (5-HT4) receptor agonist, mosapride or esophageal infusion of the transient receptor potential vanilloid receptor-1 (TRPV1) agonist capsaicin promotes secondary peristalsis.Esophageal infusion with capsaicin-containing red pepper sauce suspension does create greater mechanosensitivity as measured by secondary peristalsis than 5-HT4 receptor agonist mosapride PMID: 27438088
- Results demonstrated a role of TRPV1 as mediator of sperm thermotaxis in humans. PMID: 27992447
- There is increased expression of TRPV1 in the rectosigmoid mucosa of diarrhea-predominant irritable bowel syndrome patients. PMID: 27250983
- TRPV1 expression is upregulated in subjects with sensitive skin, and it correlates with the intensity of the symptoms. Our findings suggest a role for this receptor in the pathogenesis of sensitive skin syndrome. PMID: 26695734
- Mitogenic responses to EGF and VEGF are mediated through TRPV1 transactivation. Only in hPtEC do the increases in proliferation induced by EGF exceed those in HCjEC. Therefore, TRPV1 is a potential drug target whose clinical relevance in treating pterygium warrants further assessment. PMID: 27163769
- capsaicin stabilizes the open state of TRPV1 by "pull-and-contact" with the S4-S5 linker. PMID: 28044278
- REVIEW: role in pain and pain treatment PMID: 27240888
- By comparing the closed-state molecular dynamics simulations of TRPV1 at 30 degrees C and 60 degrees C, there were observed heat-activated conformational changes in the MPD linker, the outer pore, and the TRP helix that resemble the closed-to-open conformational changes of the protein, along with partial formation of the open-state specific hydrogen bonds. PMID: 27699868
- These findings suggest that specific molecular interactions control TRPV1 activation by particles, differential activation, and desensitization of TRPV1 by particles and/or other agonists, and cellular changes in the expression of TRPA1 as a result of I585V expression could contribute to variations in asthma symptom control. PMID: 27758864
- Acidic stimulation increased IL-8 production in LECs, whereas a selective transient receptor potential vanilloid subtype 1 (TRPV1) antagonist, 5'-iodoresiniferatoxin, decreased IL-8 production. PMID: 27312995
- Activation of TRPV1 with capsaicin attenuates neointimal formation by accelerating re-endothelialization through upregulation of Mfn2. PMID: 26947234
- Our results have demonstrated that capsaicin and resiniferatoxin form nanomolar complexes with calmodulin, and competitively inhibit TRPV1-calmodulin interaction. These interactions involve the protein recognition interface of calmodulin, which is responsible for all of the cell-regulatory calmodulin-protein interactions. PMID: 27339229
- In this review, we first describe the chemical and pharmacological properties of capsaicin and its derivatives in relation to their analgesic properties. We then consider the biochemical and functional characteristics of TRPV1, focusing on its distribution and biological effects within the somatosensory and viscerosensory nociceptive systems. PMID: 27322240
- TRPV1 overexpression attenuates isoproterenolinduced myocardial fibrosis. PMID: 27314441
顯示更多
收起更多
-
亞細胞定位:Cell junction, synapse, postsynaptic cell membrane; Multi-pass membrane protein. Cell projection, dendritic spine membrane; Multi-pass membrane protein. Cell membrane; Multi-pass membrane protein.
-
蛋白家族:Transient receptor (TC 1.A.4) family, TrpV subfamily, TRPV1 sub-subfamily
-
組織特異性:Widely expressed at low levels. Expression is elevated in dorsal root ganglia. In skin, expressed in cutaneous sensory nerve fibers, mast cells, epidermal keratinocytes, dermal blood vessels, the inner root sheet and the infundibulum of hair follicles, di
-
數據庫鏈接:
Most popular with customers
-
-
YWHAB Recombinant Monoclonal Antibody
Applications: ELISA, WB, IHC, IF, FC
Species Reactivity: Human, Mouse, Rat
-
Phospho-YAP1 (S127) Recombinant Monoclonal Antibody
Applications: ELISA, WB, IHC
Species Reactivity: Human
-
-
-
-
-